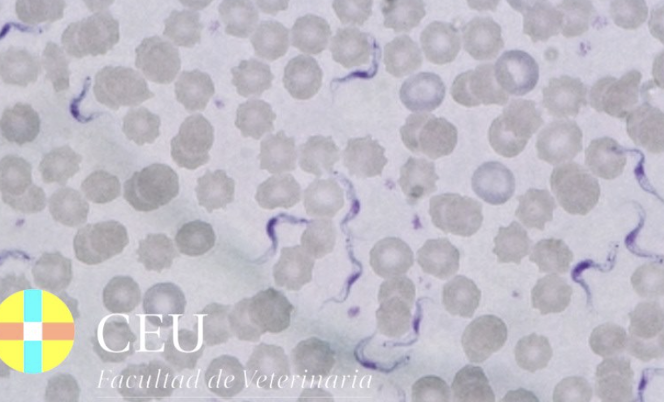
term image

1/17
Looks like no tags are added yet.
Name | Mastery | Learn | Test | Matching | Spaced |
|---|
No study sessions yet.

Entamoeba (left is cyst and right is trophozoite)

Giardia trophozoite

Giardia cyst

Trichomonas trophozoites
Trypanosoma trypomastigotes

Leishmania promastigote

Leishmania amastigote

Balantidium cyst

Balantidium trophozoite

Eimera oocyst

Cryptosporidium oocyst

Sarcocystis cysts

Toxoplasma oocysts

Babesia merozoites

Theileria merozoites

Plasmodium trophozoites

Haemoproteus gemates

Leucocytozoon gametes